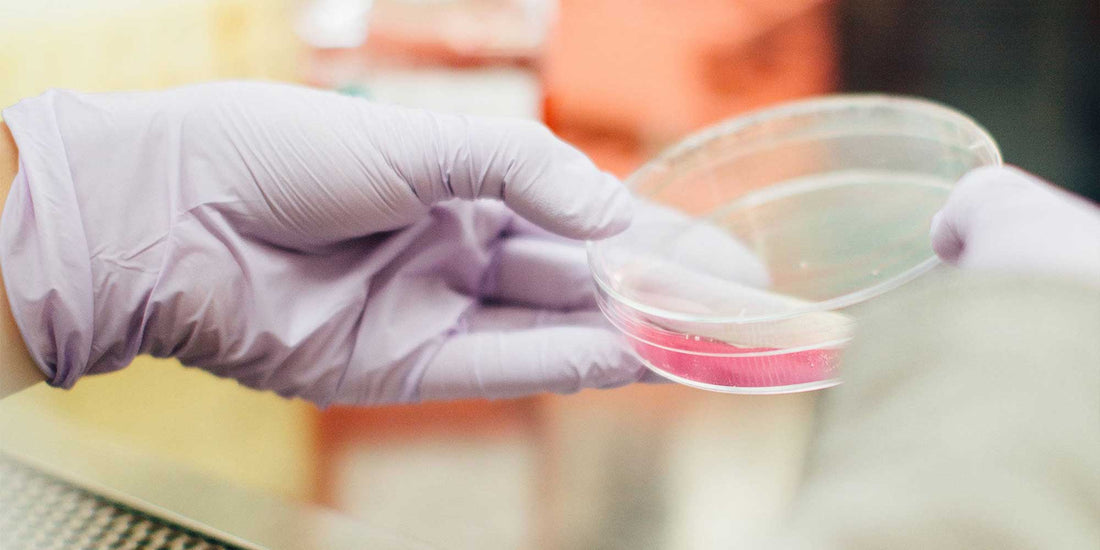

Cleaning product chemicals affecting your health
Have you ever stopped to consider the chemicals in your cleaning products? Most people don't realise the types of harmful chemicals they introduce into their home, which can have serious effects on your health, your family, pets, and the environment. One of the main concerns when purchasing cleaning products is, manufacturers are not required to list all their ingredients on product labels, so consumers never fully know the harmful ingredients they are cleaning their homes with. Another concern is some companies like to take advantage of the eco-friendly branding by advertising their products as environmentally friendly. Knowing this, we want to educate consumers on what a constitutes a green product and how to identify these products.
Some of the most harmful types of conventional cleaning products, are products such as hand sanitizers, fragranced products, fabric softeners and dryer sheets. To help consumers understand the potential risks of cleaning products, AspenClean has compiled a list of some harmful ingredients found in cleaning products and their side effects.
PHTHALATES
Phthalates are a common ingredient found in many fragranced household cleaning products, such as air fresheners, dish soaps or any sort of fragranced product. The health effects of exposure to phthalates are still being studied, as it is considered very harmful to human health. Exposure of phthalates has been linked to cancer, hormone disruption, birth defects, respiratory disease, chemical burns to eyes and skin and many more. However, the issue with buying fragranced cleaning products is, companies are not required to disclose the ingredients behind fragrances. By law, companies only have to list ingredients that are “chemicals of known concern”. However, for reasons of competition, companies argue the success of the product hinges on the secrecy of ingredients.
SULPHATES
Sulphates such as SLS and SLES, are commonly found in cleaning products such as laundry, dish and dishwasher detergents to help create a lather in cleaning power. Typically produced from petroleum, sulfates are known for irritation to skin, eyes, mouth and lungs. Though not all sulphates are considered harmful, SLES can become contaminated with 1,4 -dioxane during the manufacturing process, which has been linked to cancer in laboratory animals.
TRICLOSAN
Typically found in antibacterial cleaning products, triclosan is considered an endocrine disruptor and has been found to interfere with human's thyroid hormone metabolism. Exposure to triclosan in infancy increases a child's chances of developing allergies, asthma and eczema.
QUATERNARY AMMONIUM COMPOUNDS (QUATS)
Another harmful ingredient found in disinfectant, antibacterial and toilet cleaning products are Quaternary Ammonium Compounds (Quats). Know as a powerful irritant, exposure to Quats can lead to skin rashes like dermatitis and is linked to multiple respiratory problems such as asthma, as well as fertility issues and reproductive harm. There are also concerns that the overuse of products containing Quats can lead to antibacterial-resistant bacteria.
BUTOXYETHANOL
Butoxyethanol is used in a lot of commercial and industrial cleaning solutions such as liquid dish soap, dry cleaning solutions, degreaser applications, glass cleaners and all-purpose cleaners. Listed as a hazardous air pollutant, butoxyethanol is demonstrated to reduce fertility, as well as cause low birth weight, toxic liver metabolites, asthma and allergies.
CHLORINE
Chlorine is typically in bleach-based cleaning products like detergents, disinfectants, mildew removers and toilet bowl cleaner, but poses serious health risks to humans. Chlorinated products generate fumes that irritate lungs and are particularly dangerous for people suffering from respiratory problems such as asthma or emphysema and people with heart conditions. Listed as a hazardous air pollutant, chlorine is also considered to be highly corrosive and can damage skin, eyes.
Chlorine is also used to bleach some paper towels, napkins and tissues, which can contain dioxin that can potentially transfer to any person it comes in contact with. Dioxin has been known to affect people’s immune systems and the development of nervous systems, endocrine systems and reproductive functions and has also been classified as a known human carcinogen.
SODIUM HYDROXIDE
Sodium Hydroxide or also known as caustic soda is extremely damaging and corrosive to human tissue. Typically used in industrial cleaning, drain and oven cleaners, and some soaps and detergents, exposure to sodium Hydroxide can result in severe burns to a person’s skin. When working with sodium hydroxide, inhalation of the substance can irritate the mucous membranes of the nose, throat and respiratory tract.
HOW TO IDENTIFY GREEN CLEANING PRODUCTS
Since manufacturers are not permitted to list ingredients on their product bottles, look for third-party certifications to help identify how eco-friendly the product is.
ECOCERT CERTIFICATION
Ecocert Certification is an internationally recognized certification that guarantees the genuine practice of environmental respect throughout the formulation and manufacturing of a product. It is the leading European authority on organic and ecological certification, making it one of the largest internationally recognized organic certifications in the world. While current labelling standards tend to practice nondisclosure, all Ecocert certified products are required to have clear labelling, ensuring transparency in their communication. Currently it is not required by law for cleaning companies to disclose all their ingredients on the product label; however, an EcoCert certification requires this, including percentages.
Ecocert requirements exceed those of Ecologo and the Green Seal, which allow SLES and ethoxylated alcohols which have been linked to cancer. These certifications also allow petroleum bi-products. There are no set guidelines as to what constitutes a green product and while we commend these other certifications for initiating change, there is obviously still a way to go.
ENVIRONMENTAL WORKING GROUP (EWG)
The Environmental Working Group (EWG) is a non-profit, non-partisan organization dedicated to protecting human health and the environment. Their research shows that the cleaning industry still has a long way to go to ensure that the cleaning products we use are safe. Many brands make it difficult, if not impossible, for consumers to learn whether a product contains chemicals that can cause reproductive problems, exacerbate asthma, burn or irritate your skin or harm the environment. All AspenClean products have been rated straight A's by EWG, an achievement so far unique for a North American company making cleaning products.
LEAPING BUNNY CERTIFICATION
For all our animal lovers out there, Leaping Bunny certification is a commitment to a cruelty-free world. The Leaping Bunny certification was introduced by 8 national animal protection groups seeks to make shopping for animal-cruelty free products easier by setting clear standards. According to Leaping Bunny standards, a company is not allowed to conduct or commission animal testing of the product, ingredients or formulation. The Leaping Bunny certification stands for vegan products and a company's commitment in the fight for animal protection.
ASPENCLEAN
As a brand that is committed to eco-friendly, green cleaning products and services, discloses full transparency of all ingredients on each product bottle. All products contain only 100% natural and chemical-free ingredients, in an effort to have a clean home that won't have negative effects on your health, your home or the environment. All our products work towards a sustainable, healthy future that isn't tainted by the harmful chemicals used in conventional household cleaning products. This way, you can be sure that you clean your house the natural, environmentally friendly way, but without harmful chemicals or toxins entering your home and endangering your family.